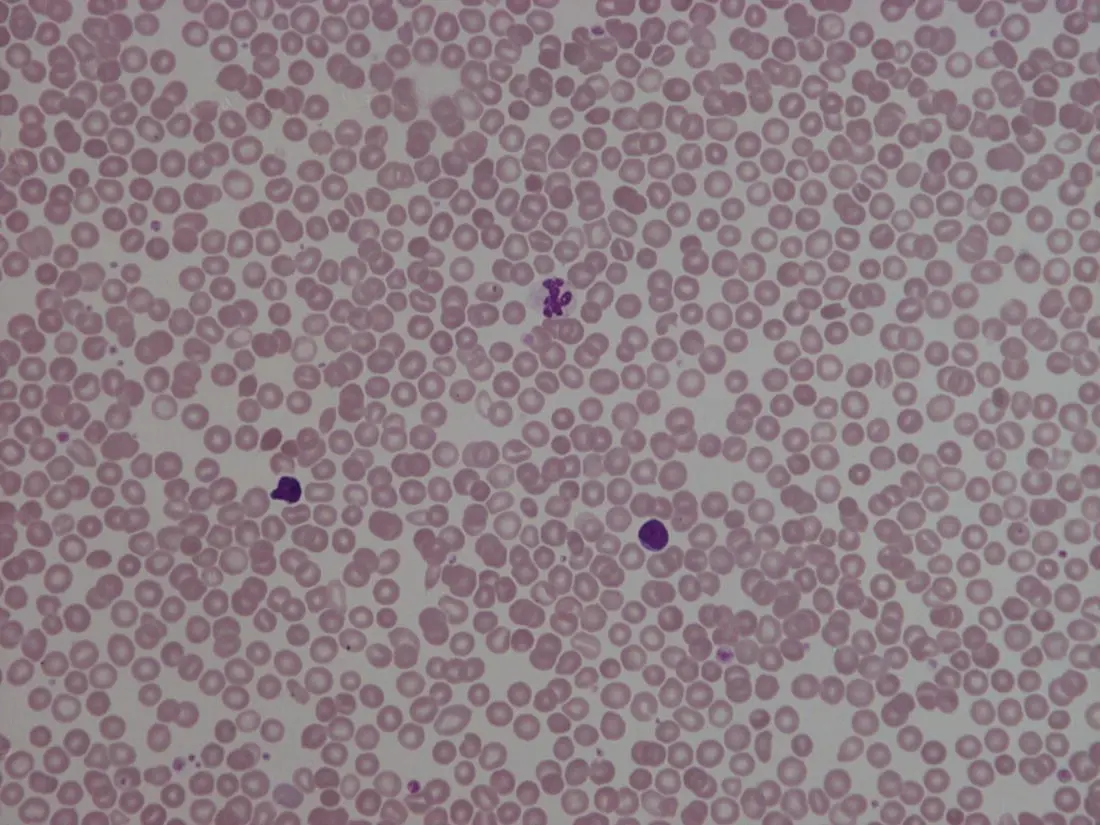

Irene Roberts - Neonatal Haematology
Здесь есть возможность читать онлайн «Irene Roberts - Neonatal Haematology» — ознакомительный отрывок электронной книги совершенно бесплатно, а после прочтения отрывка купить полную версию. В некоторых случаях можно слушать аудио, скачать через торрент в формате fb2 и присутствует краткое содержание. Жанр: unrecognised, на английском языке. Описание произведения, (предисловие) а так же отзывы посетителей доступны на портале библиотеки ЛибКат.
- Название:Neonatal Haematology
- Автор:
- Жанр:
- Год:неизвестен
- ISBN:нет данных
- Рейтинг книги:4 / 5. Голосов: 1
-
Избранное:Добавить в избранное
- Отзывы:
-
Ваша оценка:
- 80
- 1
- 2
- 3
- 4
- 5
Neonatal Haematology: краткое содержание, описание и аннотация
Предлагаем к чтению аннотацию, описание, краткое содержание или предисловие (зависит от того, что написал сам автор книги «Neonatal Haematology»). Если вы не нашли необходимую информацию о книге — напишите в комментариях, мы постараемся отыскать её.
Neonatal Haematology — читать онлайн ознакомительный отрывок
Ниже представлен текст книги, разбитый по страницам. Система сохранения места последней прочитанной страницы, позволяет с удобством читать онлайн бесплатно книгу «Neonatal Haematology», без необходимости каждый раз заново искать на чём Вы остановились. Поставьте закладку, и сможете в любой момент перейти на страницу, на которой закончили чтение.
Интервал:
Закладка:
Haemoglobin synthesis and red blood cell production in the fetus and newborn
The rates of haemoglobin synthesis and red blood cell production fall dramatically immediately after birth and remain low for the first 2 weeks of life, probably in response to the sudden increase in tissue oxygenation at birth. 35In healthy neonates the physiological rise in red cell production starts several weeks later, so that by 3 months of age a healthy infant, whatever the period of gestation at birth, should be able to produce up to 2 ml of packed red blood cells every day. 35Studies in preterm neonates have estimated that over the first 2 months of life the maximal rate of red blood cell production may be closer to 1 ml/day. This is based on the observation that preterm babies receiving therapeutic EPO are unable to maintain their haemoglobin if more than 1 ml of blood per day is venesected for diagnostic purposes but can do so where sampling losses are less than this. 36
The gestation‐related changes in globin chain synthesis in the human embryo, fetus and neonate have been studied in detail and are summarised in Fig. 1.4. 37The first haemoglobins, known as embryonic haemoglobins, are synthesised from approximately 2 or 3 weeks post‐conception, predominantly in the blood islands of the yolk sac, by the erythroblasts and red blood cells generated there. There are three embryonic haemoglobins (see Table 1.1). ζ or α globin, encoded by adjacent genes in the α globin locus on chromosome 16, combine with ε or γ globin, encoded by genes in the β globin locus on chromosome 11, to produce haemoglobin Gower 1 (ζ 2ε 2), haemoglobin Gower 2 (α 2ε 2) and haemoglobin Portland (ζ 2γ 2).
During normal human development, synthesis of embryonic haemoglobins is transient and largely restricted to yolk sac‐derived erythroblasts which are larger than those generated once definitive haemopoiesis starts in the AGM and fetal liver ( Figs 1.5and 1.6) and express different transcription factor and epigenetic programmes. From 4 or 5 weeks post‐conception, erythroblasts and red blood cells contain mainly haemoglobin F (α 2γ 2), which remains the principal haemoglobin throughout fetal life. The factors that control the switch from primitive to definitive erythropoiesis are not yet clear due to the difficulties in studying this process at such an early stage of development. Understanding more about the mechanisms which normally silence expression of ζ globin would potentially open up new ways of treating α thalassaemia major, 38an important cause of fetal and early neonatal death (see Chapter 2).

Fig. 1.4 Diagrammatic representation of the sites and rates of synthesis of different haemoglobins in the embryonic and fetal periods and during infancy.
From Bain (2020) 37.

Fig. 1.5 First trimester (8 weeks) fetal blood film showing the large size of the erythroblasts (compare with Fig. 1.6) typical of those derived from the yolk sac. These erythroblasts contain mainly embryonic globins. Note the high proportion of red cells that are nucleated and the absence of white blood cells. May–Grünwald–Giemsa (MGG), ×40 objective.

Fig. 1.6 Second trimester (14 weeks) fetal blood film showing typical erythroblasts derived from definitive haematopoiesis. These erythroblasts contain mainly fetal haemoglobin. Note the smaller size of the erythroblasts and the higher proportion of enucleated red cells compared with the first trimester ( Fig. 1.5). MGG, ×40.
The production of adult haemoglobin (haemoglobin A; α 2β 2) begins during the second trimester and remains at low levels until 30–32 weeks post‐conception, when haemoglobin A production starts to increase concomitantly with a fall in haemoglobin F production. The net result is an average haemoglobin F in term babies of 70–80% and haemoglobin A of 25–30%. 39,40After birth, haemoglobin F falls, to approximately 2% by the age of 12 months, with a corresponding increase in haemoglobin A. The molecular control of this change from haemoglobin F to haemoglobin A is termed globin switching. In recent years, there has been considerable research into the genes involved in globin switching (e.g. BCL11A ) in order to identify strategies to delay or reverse this physiological switch after birth and so maintain haemoglobin F production for children affected by severe β globin disorders such as sickle cell disease or thalassaemia major. 41,42
The timing of globin switching depends on post‐conceptional age rather than postnatal age. In fact, in term babies there is little change in haemoglobin F in the first 15 days after birth, but in preterm babies who are not transfused, haemoglobin F may remain at the same level for the first 6 weeks of life before haemoglobin A production starts to increase. This delay in haemoglobin A production (i.e. the switch from γ globin production to β globin production) can make the diagnosis of β globin disorders in the neonatal period difficult, particularly in preterm infants. This is in contrast to α globin disorders, which are almost invariably evident at birth since α globin chains are essential for the production of all but the very earliest embryonic haemoglobins (see Fig. 1.4and Table 1.1).
Red blood cell lifespan and the red blood cell membrane in the fetus and neonate
Neonatal red blood cells, particularly in preterm babies, have a shorter lifespan than adult red blood cells. Red cell lifespan is inversely proportional to gestational age at birth. Studies over 50 years ago using isotopically labelled red blood cells estimated red blood cell lifespans for preterm infants at 35–50 days, compared with 60–70 days for term infants and 120 days for healthy adults. 35More recent estimates, using mathematical modelling and transfusion of autologous cord blood cells, have also calculated the red cell lifespan in preterm neonates to be approximately 50 days. 43
The reasons for a lower red cell lifespan in neonates, although not fully understood, are thought to include the many biochemical and functional differences in the membrane of neonatal versus adult red blood cells (see Table 1.1). Known differences between neonatal and adult red blood cells include increased resistance to osmotic lysis, increased mechanical fragility, increased total lipid content with an altered lipid profile, increased insulin‐binding sites and reduced expression of blood group antigens such as A, B and I. 35Together these differences translate into the characteristic morphological differences seen in neonatal blood films, particularly in preterm neonates ( Figs 1.7– 1.9), and are associated with accelerated red cell membrane loss 44leading to reduced red cell lifespan. Indeed, the distinctive geometry of neonatal red blood cells and the membrane deformability of some of the irregularly shaped cells have been compared to the properties of red blood cells in the inherited red cell membrane disorders. 45
Fig. 1.7 Normal blood film at term. MGG, ×40.
Читать дальшеИнтервал:
Закладка:
Похожие книги на «Neonatal Haematology»
Представляем Вашему вниманию похожие книги на «Neonatal Haematology» списком для выбора. Мы отобрали схожую по названию и смыслу литературу в надежде предоставить читателям больше вариантов отыскать новые, интересные, ещё непрочитанные произведения.
Обсуждение, отзывы о книге «Neonatal Haematology» и просто собственные мнения читателей. Оставьте ваши комментарии, напишите, что Вы думаете о произведении, его смысле или главных героях. Укажите что конкретно понравилось, а что нет, и почему Вы так считаете.